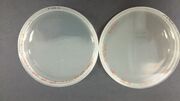

Uploads by Lindy M. Dharmawan
From OpenWetWare
Jump to navigationJump to search
This special page shows all uploaded files.
| Date | Name | Thumbnail | Size | Description |
|---|---|---|---|---|
| 16:45, 10 June 2014 | Graph.jpg (file) |  |
67 KB | |
| 15:12, 9 June 2014 | Procedure 3 copy.jpg (file) |  |
86 KB | |
| 15:02, 9 June 2014 | Procedure2 copy.jpg (file) |  |
53 KB | |
| 06:28, 8 June 2014 | Team copy.jpg (file) |  |
73 KB | |
| 06:25, 8 June 2014 | Epic team logo.jpg (file) |  |
77 KB | |
| 17:20, 6 June 2014 | Procedure 1.jpg (file) |  |
23 KB | Making LB medium, Inoculation |
| 17:15, 6 June 2014 | Procedure 3.jpg (file) |  |
62 KB | Making ATP Stock, Ligation, Transformation & Cell Culture |
| 17:09, 6 June 2014 | Procedure-2 copy.jpg (file) |  |
50 KB | Gel Electrophoresis, Nanodrop, Digestion, Gel Extraction |
| 07:43, 6 June 2014 | Alfie1.jpg (file) |  |
48 KB | |
| 07:42, 6 June 2014 | Alfie 2.jpg (file) |  |
49 KB | |
| 07:42, 6 June 2014 | Albert2.jpg (file) |  |
50 KB | |
| 07:41, 6 June 2014 | Albert1.jpg (file) | |
45 KB | |
| 07:40, 6 June 2014 | Imageedit 3 2290946509.jpg (file) |  |
47 KB | |
| 07:39, 6 June 2014 | Imageedit 2 6329335469.jpg (file) |  |
51 KB | |
| 06:45, 6 June 2014 | 20140606131708644.jpg (file) |  |
376 KB |